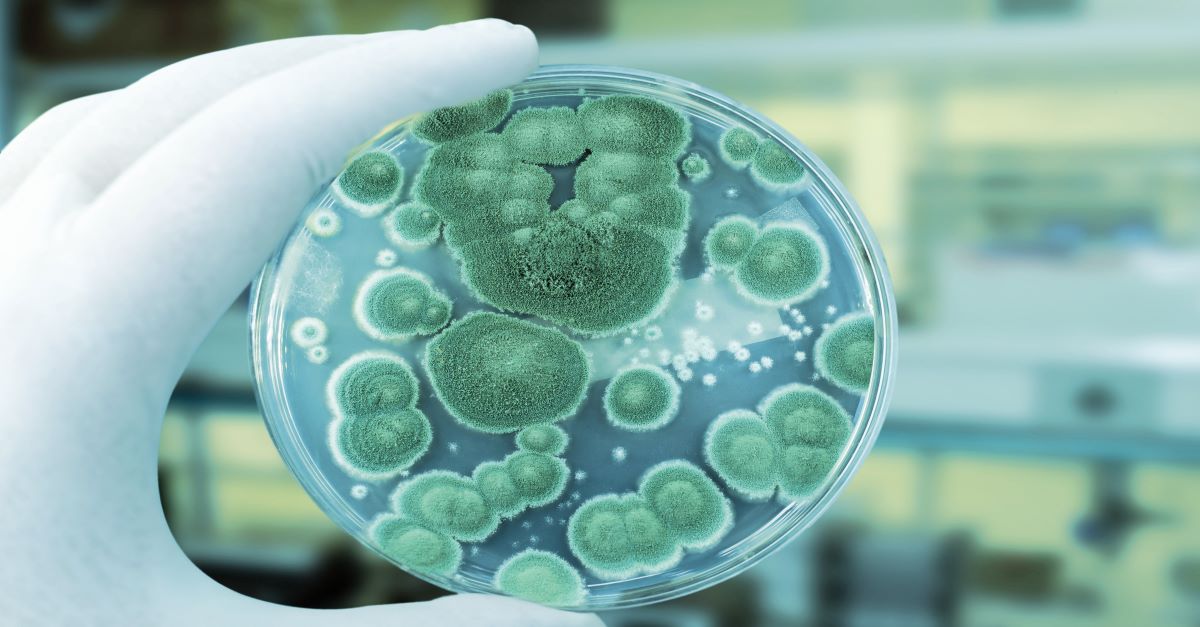

The new EU GMP Annex 1 requires manufacturers of sterile medicinal products to have a clear plan for preventing contamination of their finished products by microorganism, particulate, or pyrogen. One of the main hurdles that you must overcome to achieve this, as outlined in the new Annex 1, is to develop a facility-wide contamination control strategy, focused on deploying a continuous monitoring approach for Grade A environmental monitoring.
So how do you optimize your facility's contamination control strategy to uphold Annex 1? AUTOMATION.
Testing and analyzing samples for microbiological quality control (QC), i.e. environmental monitoring and bioburden testing, is typically a time-consuming, manual process. Lab personnel must spend valuable time on subjective enumeration, repetitive sample analysis, and error-prone recordkeeping steps. The Growth Direct® system is an automated rapid microbial method (RMM) that overcomes these challenges, integrating novel growth-based technology with advanced robotic automation, powerful optical imaging, algorithmic vision analysis, and data management. The synergy of these innovations results in fast, accurate environmental monitoring and bioburden testing that can boost productivity in your microbial QC lab while allowing you to uphold the requirements of the new EU GMP Annex 1.
.jpg)




.jpg)